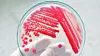

Antibiotikaforbruket til dyr ned i EU
Norge er fortsatt blant landene i EU/EØS med desidert lavest antibiotikaforbruk til matproduserende dyr. Men nå kommer de andre litt etter.
Norge er fortsatt blant landene i EU/EØS med desidert lavest antibiotikaforbruk til matproduserende dyr. Men nå kommer de andre litt etter.